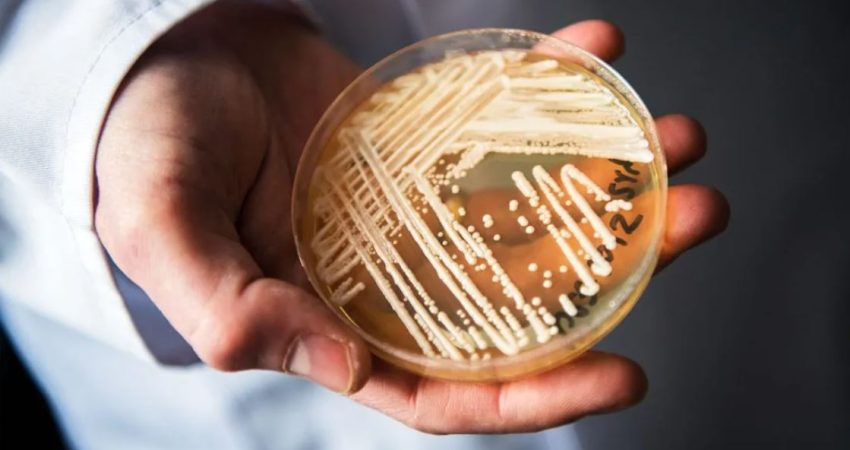

Candida auris është një infeksion mykotik që shkakton kandidiazën, një sëmundje seksualisht e transmetueshme. Në faza të rënda kjo sëmundje mund të shkaktojë rezistencë ndaj ilaçeve.
Kandidiaza është një nga infeksionet më të shpeshta të marra në ambientet spitalore. Studimet kanë treguar se më shumë se 90% e infeksioneve Candida auris, ishin rezistente ndaj të paktën një ilaçi.
Gati gjysma e pacientëve që kontraktojnë Candida auris vdesin brenda 90 ditëve, sipas CDC-së në SHBA.
Infeksioni shpesh prek pacientët të shtruar në spital, mund të zhvillohet disa javë pas shtrimit në spital.
Simptoma më e zakonshme e infeksionit invaziv Candida është temperatura, e cila nuk përmirësohet pas terapisë me antibiotikë të përshkruar për një infeksion bakterial. Megjithatë, simptomat ndryshojnë sipas organizmit të pacientit dhe shpesh mund t’i atribuohen patologjive të tjera bashkë-ekzistuese.
Faktorët e rrezikut për infeksionet Candida auris, janë të ngjashëm me ata për llojet e tjera të Candida dhe gjenden te pacientët e të gjitha moshave, nga foshnjat deri tek të moshuarit.

Deri më tani, janë shkaktuar më shpesh infeksione të qarkullimit të gjakut, infeksione intra-abdominale, infeksione të plagëve dhe infeksione të veshit. Aktualisht është e paqartë nëse mund të shkaktojë infeksione të mushkërive dhe fshikëzës.
Ekzistojnë tre klasa të anti-mykotikëve që përdoren për të trajtuar infeksionet invazive: azole, polien dhe ekinokandin. 90% e rasteve të izoluara janë rezistente ndaj të paktën njërit nga këta tre ilaçe dhe gjithnjë e më shpesh ato gjenden me profile më komplekse, të pashërueshme të rezistencës.
Megjithëse rezistenca ndaj azoleve dhe polieneve është shumë e zakonshme.
Rastet (mbi një mijë) të infeksionit me C. auris po rriten, me shpejtësi globalisht, sipas studimeve të Ministrisë së Shëndetësisë në Itali.
“Të dhënat tregojnë se rastet janë kryesisht meshkuj, shumë prej tyre vuajnë nga sëmundje të tilla si diabeti, sëmundjet e veshkave dhe veshit. Më shumë se gjysma e rasteve kanë histori të kateterit venoz qendror dhe përdorimit të antibiotikëve me spektër të gjerë”, thuhet më tej në studim.
Infeksioni transmetohet nga kontakti i drejtpërdrejtë me një person të infektuar, ose nga kontakti indirekt me objekte, pajisje dhe sipërfaqe të kontaminuara.
Burimi: La Stampa/ Përshtati: Gazeta “Si”
Copyright © Gazeta “Si”
Të gjitha të drejtat e këtij materiali janë pronë ekskluzive dhe e patjetërsueshme e Gazetës “Si”, sipas Ligjit Nr.35/2016 “Për të drejtat e autorit dhe të drejtat e tjera të lidhura me to”. Ndalohet kategorikisht kopjimi, publikimi, shpërndarja, tjetërsimi etj, pa autorizimin e Gazetës “Si”, në të kundërt çdo shkelës do mbajë përgjegjësi sipas nenit 179 të Ligjit 35/2016.
.png)

Lini një Përgjigje